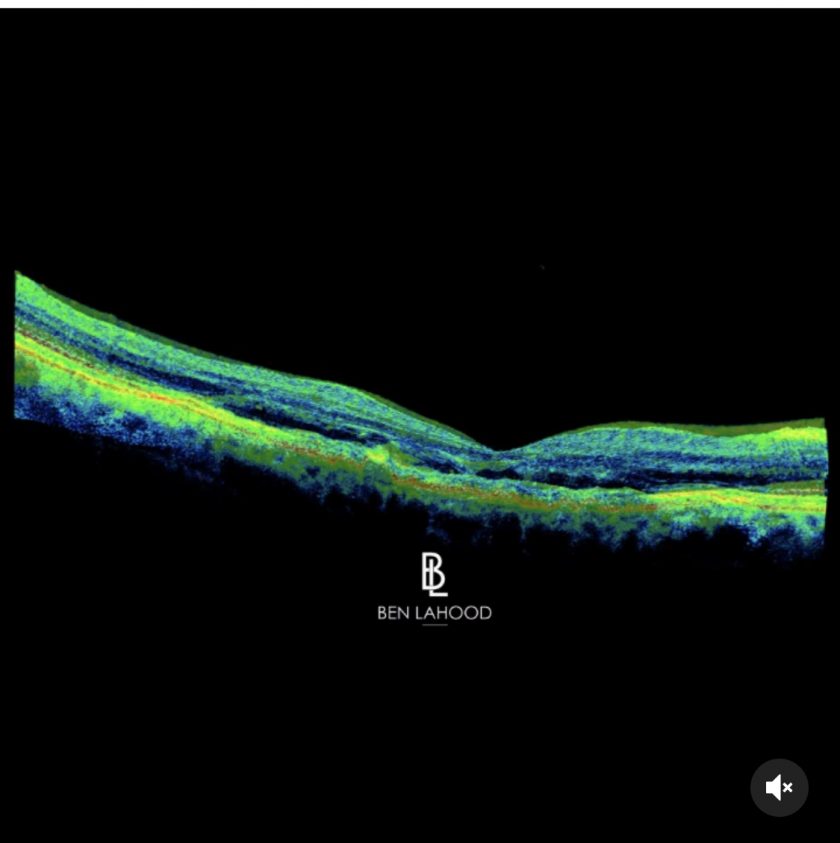
Dr Ben LaHood Logo

The power of an Injection in the treatment of wet macula degeneration
Just one injection of Eylea transformed this patient’s wet ARMD to dry over the course of a month.
I made a video of her progress on OCT imaging to highlight the vast improvement. You can see the large black areas of swelling beneath the retina disappear, her fovea becomes defined again and despite the remaining drusen, visual acuity has also made improvement.
When I started training, the first anti-vascular endothelial growth factor medications had just been introduced. My first journal publication was a randomised trial to asses which method of anaesthesia for injection was most effective. It won me the prize for best presentation at RANZCO congress that year.
Approximately 10,000 injections later and the results never fail to amaze me. Its incredible to think that prior to injections such as Avastin, Lucentis and Eylea, management of wet macula degeneration was registration with the blind foundation. These drugs were truly a revolutionary step for eye care around the world. Our only problem now is with a successful treatment and an ageing population, eye clinics are overwhelmed with the volume of injections required.
My advice when educating on this is to always have a low threshold for having eyes checked with any distortion of straight lines or patchy vision. I feel that often the cases we catch early do better long term. A publication about supplements for ARMD I co-authored is available to help guide patients and clinicians about which supplement may be most useful.




